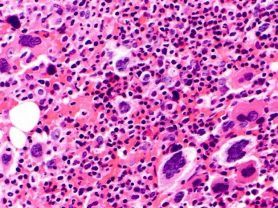

Inflammation and genetic mutations can drive cardiovascular complications in patients with myeloproliferative neoplasms, which include disorders such as polycythemia vera, essential thrombocythemia, and primary myelofibrosis.
Certain patients with myeloproliferative neoplasms (MPNs) face elevated cardiovascular risk, as multiple mechanisms can work separately or in tandem to put individuals at higher risk of heart failure, pulmonary hypertension, and cardiac fibrosis, according to authors of a new review.
Bone marrow from patient with primary myelofibrosis stained with hematoxylin and eosin | Image credit: MD Anderson
The analysis, "Cardiovascular Risk in Philadelphia-Negative Myeloproliferative Neoplasms: Mechanisms and Implications—A Narrative Review,” appears in Current Issues in Molecular Biology. It states that inflammation and genetic mutations can drive cardiovascular complications in patients with MPNs, which include disorders such as polycythemia vera (PV), essential thrombocythemia (ET), and primary myelofibrosis (PMF).
Patients with these MPNs have higher risk of cardiovascular morbidity and mortality, although just how much varies by condition. ET has the best prognosis, the authors write, just how much varies by condition. ET offers the longest life expectancy following diagnosis, the authors write, followed by PV and PMF, although the median survival for PMF has improved in recent years, “due to increased awareness and advancements in treatment options.”
The authors review the mechanism of inflammation and its relationship to cardiovascular burden before discussion other contributors.
“Chronic inflammation worsens cardiovascular complications by promoting clonal expansion and increasing leukocyte and platelet production.,” the authors state. Heart failure and pulmonary hypertension, meanwhile, are “linked to JAK-STAT pathway activation,” fueling the cardiovascular risk in these patients.
A key element, relative to prior reviews of inflammation and MPNs, is new research into microRNAs (miRNAs) and role in cardiovascular risk in patients with MPNs. The various factors, the authors suggest, could lead to multiple therapeutic targets.
First, the authors discuss the roots of “fight or flight” origins of inflammation and the role of cytokines, notably interleukin-1 beta, which left unchecked leads directly to MPN progression. Some cytokines are more likely than others to be associated with increased white blood cells, the need for transfusions, and progression to myelofibrosis. “The overproduction of cytokines leads to the activation of thrombocytes, leukocytes, and endothelial cells,” the authors wrote. “This activation leads to mixed leukocyte–platelet aggregates, which disrupt normal coagulation and cause thrombosis and tissue ischemia.”
Prior autoimmune conditions don’t help, and here the JAK2-V617F variant plays a role. It has been seen in endothelial cells, and the authors state that white blood cells attach “more firmly “ this ECs mutated by this variant than regular cells. This variant increases thrombotic risk, which is seen in 40% of PV patients; the authors write that these events are also elevated in ET patients who carry the JAK-V617F anomaly.
This inflammatory environment of these conditions, the authors write, can cause an overexpression of tissue factor, a protein need for blood clotting; because elevated cytokines are already common in MPNs, this unhealthy mix can further fuel tissue factor expression, triggering even more inflammation. All this contributes to platelet production and fibrosis.
Thrombosis in PV. The authors write, “Thrombosis and cardiovascular complications are notably more prevalent in PV compared to other myeloproliferative disorders. Studies indicate that nearly 40% of PV patients experience either minor or major thrombotic events, with vascular-related deaths accounting for 35% to 45% of all fatalities in PV cases.”
Assessments are critical, and drug-related hypertension is often missed, the authors say. They discuss pathways that contribute to thrombotic events when the JAK2-V617F mutation is present. JAK2 belongs to cytoplasmic tyrosine kinase family members responsible for mediating signal transduction from cell surface cytokine receptors like erythropoietin and thrombopoietin receptors When JAK2 variants and clonal hematopoiesis of indeterminate potential (CHIP) are both present, risk is even greater. These patients are more likely to develop myelodysplastic syndromes
Finally, the authors discuss the connections between JAK2-V617F and excess cholesterol production, putting patients at higher risk of atheroschlerosis.
MicroRNAs. A final section of the review discussed a host of miRNA biormarkers associated with cardiovascular disease and their links to the JAK-STAT pathway. “A recent investigation of peripheral blood CD34+ cells in PV patients found that miR-196b is downregulated in both male and female patients. This deregulation of stem-progenitor cell miRNAs might play a role in the clonal expansion of JAK2V617F,” the authors wrote. “Continued research in this area could provide deeper insights into MPN pathogenesis and help identify potential targets for therapies aimed at eradicating the disease.”
Reference
Todor SB, Ichim C, Boicean A, Mihaila RG.Cardiovascular risk in Philadelphia-negative myeloproliferative neoplasms: mechanisms and implications—a narrative review. Curr Issues Mol Biol. 2024;46:8407–8423. https://doi.org/10.3390/cimb46080496.